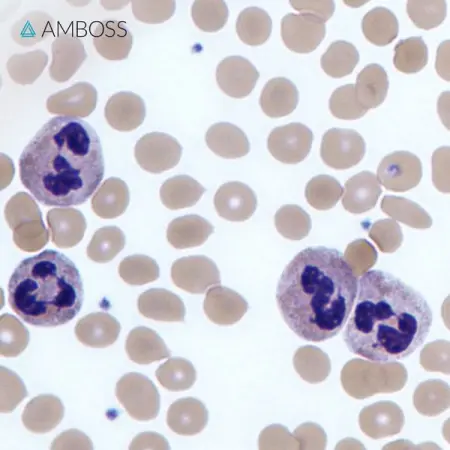
Step1 quiz time!

A 13-year-old girl is brought to the physician by he

Step1 quiz time!
A 13-year-old girl is brought to the physician by her parents because of a 1-week history of fever and fatigue. During this period, she has also had decreased appetite and a 1.5-kg 3.5-lb weight loss. Her temperature is 39.2C 102.5F, pulse is 118min, respirations are 16min, and blood pressure is 11070 mm Hg. Physical examination shows cervical lymphadenopathy. Laboratory studies show a hemoglobin concentration of 15 gdL, a leukocyte count of 21,000mm3, and a platelet count of 320,000mm3. A peripheral blood smear is shown. Which of the following is the most likely cause of the findings on this patients peripheral blood smear?
A - Acute viral infection
B - Burkitt lymphoma
C - Acute lymphoblastic leukemia
D - Acute bacterial infection
E - Acute myeloid leukemia
F - Acute parasitic infection
AMBOSS.COM
Test Your Step 1 Knowledge
Go for a high-yield Qbank
Learn More
Some descriptions are auto translated, meaning might have changed a little or a lot.

Email:
Contact Number:
Age: 49 (report if not 18+)
REPORT
Post your own ad > get emails > Select one > Start dating.
*You must be 18+.
POST AD NOW
BackpageAfrica.com is a Backpage Equivalent african website with a good control at user level, community level. BackpageAfrica.com is a classified web app like a regular classified website. It is similar to craigslist personals, gumtree, backpage, bedpage for personal ads.
Disclaimer: Please ignore under 18 users, we highly discourage them. Any ad misleading, prone to human traffiking, outlawed, scamming will be removed without prior notice.
Cheating Alert! Cheating is everywhere, stay cautious. Any advertise if asks for up front, gifts, any login data or any means of payment may be somebody behind a scam and use your brain to avoid such a trap. Backpage Africa does not encourage scam party, cheating people.
Copyright: Backpage Africa (c) 2025 | Privacy Policy | Contact Us